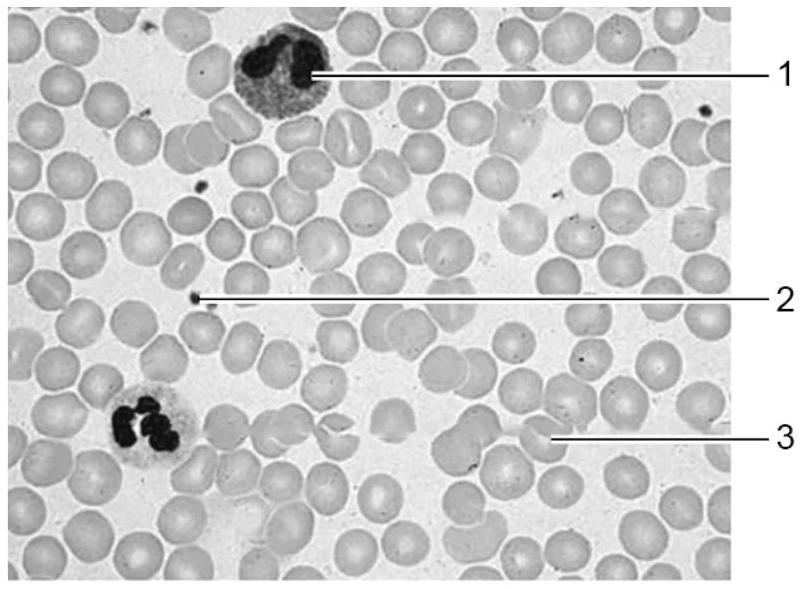
afbeelding 2

Toen Eileen zes jaar oud was, kreeg ze last van extreme vermoeidheid, infecties en bloedingen. Ze bleek Fanconi-anemie te hebben.
Fanconi-anemie (FA) is een zeldzame erfelijke ziekte waarbij er onder andere een verminderde aanmaak is van de vaste bloedbestanddelen.FA wordt meestal veroorzaakt door een mutatie die aanwezig is in een autosomaal gen, het FANCA-gen. Het mutante allel is recessief. Normaal gesproken regelt het FANCA-gen dat DNA gerepareerd kan worden.Fanconi-anemie kan ook ontstaan door een mutatie die aanwezig is in een gen op het X-chromosoom. Ook dit mutante allel is recessief.Bij Eileen is FA het gevolg van autosomale overerving. In afbeelding 1 staat de stamboom van de familie van Eileen. |